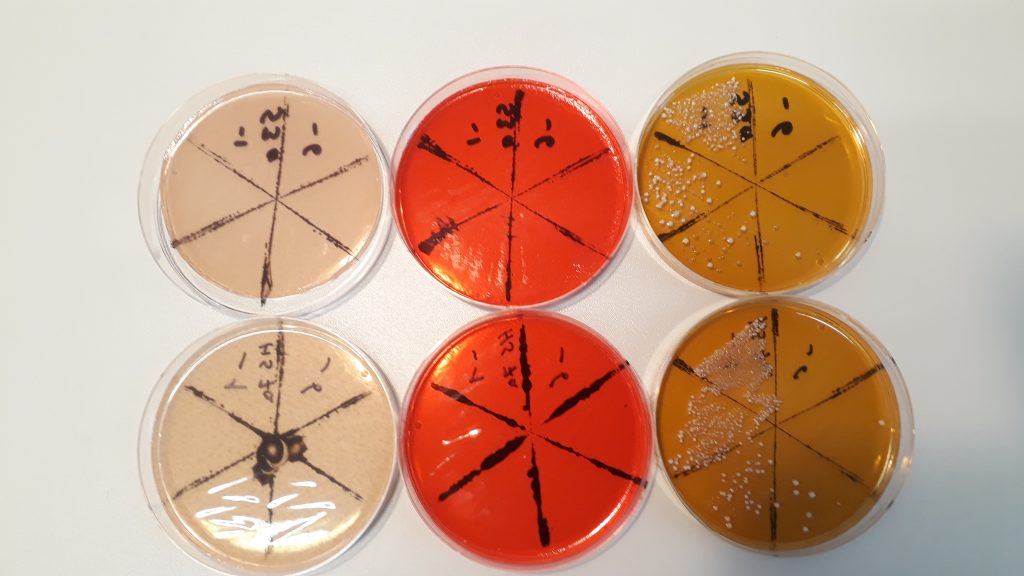

Can lactic acid fermentation disinfect manure?
[[{“value”:”
Can lactic acid fermentation disinfect manure?
Cow manure is a valuable fertiliser but can also be a biohazard as it can contain harmful bacteria. It is important to kill off pathogens before manure is spread on fields, but disinfection at such a scale is not easy, and current methods have their drawbacks. At the Friedrich Loeffler Institute in Germany, microbiologist Dr Hannah Halm and veterinarian Dr Sören Woelke are testing whether lactic acid fermentation can disinfect manure, providing an effective new way of controlling pathogens.
Talk like a microbiologist
Anaerobic — in the absence of oxygen
Biogas — a renewable source of gas, produced by fermenting organic waste
Lactic acid — an organic acid produced by various processes, such as metabolism and in muscles during strenuous (anaerobic) exercise
Lactic acid bacteria (LAB) — beneficial bacteria that ferment carbohydrates (including sugars) to make lactic acid
Lactic acid fermentation — an anaerobic metabolic process that converts carbohydrates (including sugars) into cellular energy and lactic acid
Microbe — a microscopic organism, such as a bacterium or virus
Pathogen — a harmful microbe
Salmonella — a group of harmful bacteria that causes salmonellosis disease
Salmonella bacteria are not to be trifled with. They are one of the most common serious contaminants in foods, the most notorious example being in raw chicken. “In humans, common symptoms of salmonellosis include diarrhoea, fever, abdominal cramps and vomiting,” says Dr Hannah Halm, a microbiologist at the Friedrich Loeffler Institute.
Other animals can also be infected by salmonella, and contaminated faeces are a primary way that the bacteria are spread. This is a problem for cow farming as, if an outbreak of salmonella occurs on a farm, all the manure produced by infected cows will be contaminated. Hannah and her colleague, veterinarian Dr Sören Woelke, are studying how other types of bacteria could be used to disinfect manure contaminated with salmonella, reducing disease risks for humans and livestock alike, and helping farms become safer and more efficient.
Current disinfection methods
Methods to disinfect contaminated manure already exist, but none of them are ideal. Depending on the treatment, the manure can then be spread on fields in limited quantities as fertiliser, which returns valuable nutrients to the soil. “Various chemicals, such as lime or caustic soda, can be added to manure to destroy bacteria,” says Sören. “However, these can lead to the release of dangerous gases like hydrogen sulphide.”
Manure can also be decontaminated by heating it in biogas facilities. The heat kills the pathogens, then the manure is broken down by microbes in various processes in the fermenter. At the end of this process, methane is produced, which is collected and used as fuel. However, this process relies on transporting the manure to a biogas facility, which creates opportunities for pathogens to spread.
A third option is simply to store the manure until the dangerous bacteria have died, at which point it can be used as fertiliser. But this takes between three and six months, and many farms do not have the space to safely store large quantities of manure for this long.
LAB in the lab
Lactic acid is commonplace in biology. You may have come across it in human physiology, as a by-product of intense exercise, but it is also the product of an important group of microbes, known collectively as lactic acid bacteria (LAB). “LAB occur naturally in the guts of mammals, where they help with digestion,” says Hannah. “They are also used in food preservation, for instance to make pickles, sauerkraut and yoghurt.” LAB break down carbohydrates (including sugars) into lactic acid via the process of lactic acid fermentation.
Hannah and Sören wanted to investigate whether lactic acid fermentation can be used to disinfect contaminated manure through a process that can be easily undertaken on farms. “We used sucrose (regular household sugar), as an initial food for the bacteria to start fermentation, and oats, to provide longer-chain carbohydrates to keep the fermentation going,” says Hannah. “Our experiments were all performed under anaerobic conditions, which LAB need to metabolise effectively.” They settled on oats for the carbohydrate source via trial-and-error. They first tried the process using hay, as it is more readily available on most farms, but fermentation was too slow. “Oats proved effective, and in theory any cereal should work just as well, though we need to test this,” says Sören.
Reference
https://doi.org/10.33424/FUTURUM678


Hannah and Sören prepared test tubes of cow manure mixed with specific amounts of sucrose and oats, then added salmonella bacteria (keeping some test tubes without salmonella as control samples) and put the test tubes in an incubator. They repeated the experiments with the incubator set to different temperatures to test the effect of temperature on fermentation.
Top results
When the results came in, Hannah and Sören were astounded by their findings. “We expected that salmonella would be reduced in the samples, but we found that lactic acid fermentation inactivated salmonella completely,” says Hannah. “We were unable to detect salmonella at all.” The exact mechanisms by which this happens are still not totally clear. “We suspect it’s the combination of various processes, such as acidification of the manure and the release of volatile fatty acids, that leads to this inactivation.” Hannah and Sören also discovered that fermentation (and, therefore, inactivation of salmonella) happens faster at warmer temperatures.
While the lab results were conclusive, it was then necessary to test the process at scale to make sure it was applicable for farms in the real world. “Our colleagues at the University of Hohenheim scaled up our experiments to the size of farm containers,” says Sören. “They showed that lactic acid fermentation also works at the farm scale.”
From the lab to the farm
Lactic acid fermentation has several advantages over other methods currently used for disinfecting manure. It does not use dangerous chemicals or produce dangerous gases, it does not need transportation to a site off the farm, and the process is relatively quick, so the manure does not take up limited storage space for a long time.
Hannah and Sören are optimistic that this process could soon be rolled out in farms across Germany and beyond. “The implementation is relatively simple,” explains Hannah. “The manure is stored in a nearly airtight container and the carbohydrates are added. Then, it’s left alone.” Within a week, the pH should drop significantly (i.e., become more acidic). In warm conditions, the fermentation should be complete within four to six weeks, and the mixture should be salmonella-free. This process could help farms become much more efficient, helping farmers to produce food at a lower cost and through safer and more environmentally friendly means.
 Dr Hannah Halm
Dr Hannah Halm
Dr Sören Woelke
Federal Research Institute for Animal Health, Friedrich Loeffler Institute, Germany
Field of research: Microbiology
Research project: Investigating lactic acid fermentation as a method to disinfect cow manure containing salmonella
Funder: German Federal Ministry of Research, Technology and Space
About microbiology
Microbiology is the study of microbes – microscopic organisms including bacteria, viruses, algae and amoebas. It is a broad and interdisciplinary field. “There are interactions with genetics, molecular biology, bioinformatics and molecular ecology, to name just a few,” says Sören, who combines his work as a veterinarian with microbiology research.
Careers in microbiology are diverse and varied. Hannah divides them roughly into ‘clean’ and ‘dirty’. “‘Clean’ microbiology is clinical microbiology,” she explains. “There are career possibilities in hospital labs or university research labs as a biological scientist or technician. But if you prefer getting your hands dirty out in the field, I recommend environmental sciences. In addition to roles in universities, there are career possibilities in analytical labs and for environmental authorities.”
The working life of a microbiologist is also varied. “No day is like another,” says Hannah. “I might find myself taking samples in the lab, counting bacterial colonies or processing data.” There is a lot of collaboration as experiments are planned with colleagues, and results are discussed to decide how they can be interpreted and what comes next. “Ideally, our results will be published as a paper or presented at a conference,” says Hannah. “Preparing for that involves a lot of time in front of the computer and drinking too much coffee!”
And, like any science, things don’t always go to plan. “Often, experiments don’t work the first time,” says Hannah. “You need a high tolerance for frustration. But once everything has worked out and results have emerged, you realise that all the hard work has paid off, and it’s a great feeling!”
Pathway from school to microbiology
At high school, Hannah recommends getting a good grounding in biology, chemistry (especially organic chemistry), maths (especially statistics) and physics.
“At university, I recommend studying what you are most interested in,” says Hannah. “Whichever topic you decide will become more interesting as you study it and explore the unknowns.” Useful degrees to consider include microbiology, biology, biochemistry, biomedical science and veterinary studies.
Explore careers in microbiology
Most microbiology careers will involve working in a laboratory to study and analyse microbes, which could be in a hospital, veterinary clinic, university or other research institution.
The American Society for Microbiology gives a good overview of different careers in microbiology: asm.org/articles/2018/november/careers-in-microbiology-and-the-microbial-sciences
The Friedrich Loeffler Institute, where Hannah and Sören work, offers internships and other opportunities for young academics: fli.de/en/career/young-academics
Meet Hannah
 I’ve always had a lot of varied interests. I’ve played the violin since I was eight and practised martial arts since I was seventeen. I watched a lot of animal documentaries when I was younger, and I’ve always had a strong interest in insects.
I’ve always had a lot of varied interests. I’ve played the violin since I was eight and practised martial arts since I was seventeen. I watched a lot of animal documentaries when I was younger, and I’ve always had a strong interest in insects.
In the school summer holidays, I attended a children’s programme at my local natural history museum. There, I looked in a microscope for the first time, and I realised that there were a lot of secrets in nature. I went on to study biology at university and became a marine biologist, focusing on algae.
My PhD was about marine biogeochemistry and molecular ecology. Defending my PhD was scary but also the happiest and proudest day of my life. Since then, I’ve studied microbiology of the deep biosphere (life below the Earth’s surface), oncology (cancer research) and how to isolate bacteria from samples, gaining extensive methodological knowledge in the process, before finally landing in my current position. So you see, life paths do not have to be straight!
Curiosity and fascination with the living world have always driven me. When problems arise, persistence helps me find solutions. I like to think outside the box and enjoy listening to lectures from completely different fields, which helps keep me open-minded about other perspectives.
In my free time, I like to make music and play sports. I still play the violin in an orchestra, and I’m still fascinated by insects!
Hannah’s top tips
1. Always keep your eyes open and nurture your curiosity.
2. Stay persistent and never give up.
3. Make friends with statistics!
Meet Sören
 I had lots of hobbies as a teenager. I had lots of pets and was interested in aquariums and exotic animals. I played American football, which taught me about self-discipline and perseverance. And I enjoyed meeting up with friends after school to have fun.
I had lots of hobbies as a teenager. I had lots of pets and was interested in aquariums and exotic animals. I played American football, which taught me about self-discipline and perseverance. And I enjoyed meeting up with friends after school to have fun.
I went to university to study veterinary medicine where I developed an interest in bovine (cow) medicine. Then, when I did an immunology internship during my studies, I decided I wanted to work in science as well. I gained extensive experience in the field of animal manure and microbiology, which has become a significant area of interest for me.
The metaphor of the battle of David against Goliath is particularly relevant to the remarkable way that a tiny microorganism can exert a substantial influence on an entire animal population. The COVID-19 pandemic also demonstrated the vulnerability of modern civilisation to microscopic pathogens.
When I’m not working, I love spending time with my family. I enjoy jogging to balance out my lab work, and gardening is a great way to feel grounded in what really matters.
Sören’s top tips
1. Be curious. Seeing the world through the inquisitive eyes of a child, whatever your age, is incredibly valuable.
2. Be honest. This can sometimes be a challenge, as nobody likes to admit mistakes. Start by being honest with yourself, and do what you believe in.
3. Don’t commit yourself to plans for your entire future. You need to experience the world around you before you can identify your true interests.
Do you have a question for Hannah or Sören?
Write it in the comments box below and they will get back to you. (Remember, researchers are very busy people, so you may have to wait a few days.)

Discover how microbiologists are helping farmers by investigating the effects of fungicides:
futurumcareers.com/fields-and-fungicides-mixing-microbiology-and-social-science
The post Can lactic acid fermentation disinfect manure? appeared first on Futurum.
“}]]